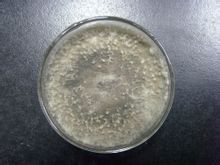
交鏈孢屬 交鏈孢屬

基本內容
分生孢子梗較短,單生或叢生,大多數不分枝,與營養菌絲幾乎無區別。分 生孢子呈紡錘狀或倒棒狀,頂端延長或成喙狀,多細胞,有壁磚狀分隔,常數個成鏈,一般為褐色。尚未發現有性世代。
交鏈孢屬(Alternaria)菌絲暗褐、灰黑色至黑色。是土壤、空氣、工業材料上常見的腐生菌,有的是栽培植物的寄生菌。某些種可用於甾族化合物轉化。
分生孢子梗較短,單生或叢生,大多數不分枝,與營養菌絲幾乎無區別。分 生孢子呈紡錘狀或倒棒狀,頂端延長或成喙狀,多細胞,有壁磚狀分隔,常數個成鏈,一般為褐色。尚未發現有性世代。
玉米交鏈孢葉斑病,葉片發病後在葉面產生褪綠的長條狀病斑,病斑中部逐漸變為灰褐色,邊緣呈紫色,病斑沿葉脈方向迅速擴展。播種或移栽前,清除田間及四周雜草,集...
基本信息 為害症狀 形態特徵 傳播途徑以及發病條件 發病因素病菌以菌絲體或分生孢子在留種母株、種子表面、病殘體上或留在土壤中越冬或越夏,成為翌年初侵染源.成為翌年初侵染源,分生孢子借氣流傳播蔓延,形成再侵染,使該...
基本信息 為害症狀 病原形態特徵 傳播途徑和發病條件 防治方法鏈格孢黴菌屬於絲狀真菌, 是一種普遍存在於環境中的病原體和腐生菌, 是低溫環境下導致水果、蔬菜等農產品腐爛變質的主要微生物。 鏈格孢黴菌產生的多種次級代...
分布及類型 生態學及污染 毒性作用 產毒培養 檢測方法鏈孢霉(Neurospora)亦叫脈孢霉、粗糙脈孢霉(N.crassa)、紅麵包霉,俗稱紅黴菌,紅娥子,常見的有粗糙脈孢菌和間型脈孢菌。在分類學上屬子囊...
該病主要發生在甜瓜生長中後期,危害葉片、莖蔓和果實,下部老葉先發病,葉斑近圓形、褐色,具不明顯輪紋。果實染病多發生在日灼或其它病斑上,布滿一層黑色霉狀物...
瓜鏈格孢 相關連線 [症狀] [病原] [發病規律]淡紫灰鏈黴菌NRRL2675,鏈黴菌科、屬放線菌的一種。孢子絲直,孢子卵狀。產生瓦拉殺菌素(valacidin),可以防治植物細菌病害(如菜豆疫病黃單胞...
基本信息 形態特徵 性狀特徵 形態描述 討論,從專業的角度系統介紹了果蔬中棒麴黴素、赭麴黴素、交鏈孢毒素、單端孢霉烯...第四章果蔬中交鏈孢毒素/38第一節果蔬中交鏈孢毒素的產生/39一、交鏈孢毒素概況/39二、交鏈孢毒素的產生和污染狀況/40第二節交鏈...
名詞釋義蘑菇又名雙孢蘑菇、白蘑菇、洋蘑菇、蒙古蘑菇、蘑菰、肉菌、蘑菇菌...考證:出自《神農本草經》 科屬分類:蘑菇科 性味:微寒、性涼、味甘、入肝...的通稱為蘑菇,學名為雙孢蘑菇。從野生種類中進一步篩選馴化優質生產菌種大有...
名詞釋義 基本信息 生物性狀 藥理作用 食用品種